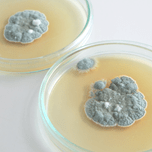
Penicillium in air coinditioners
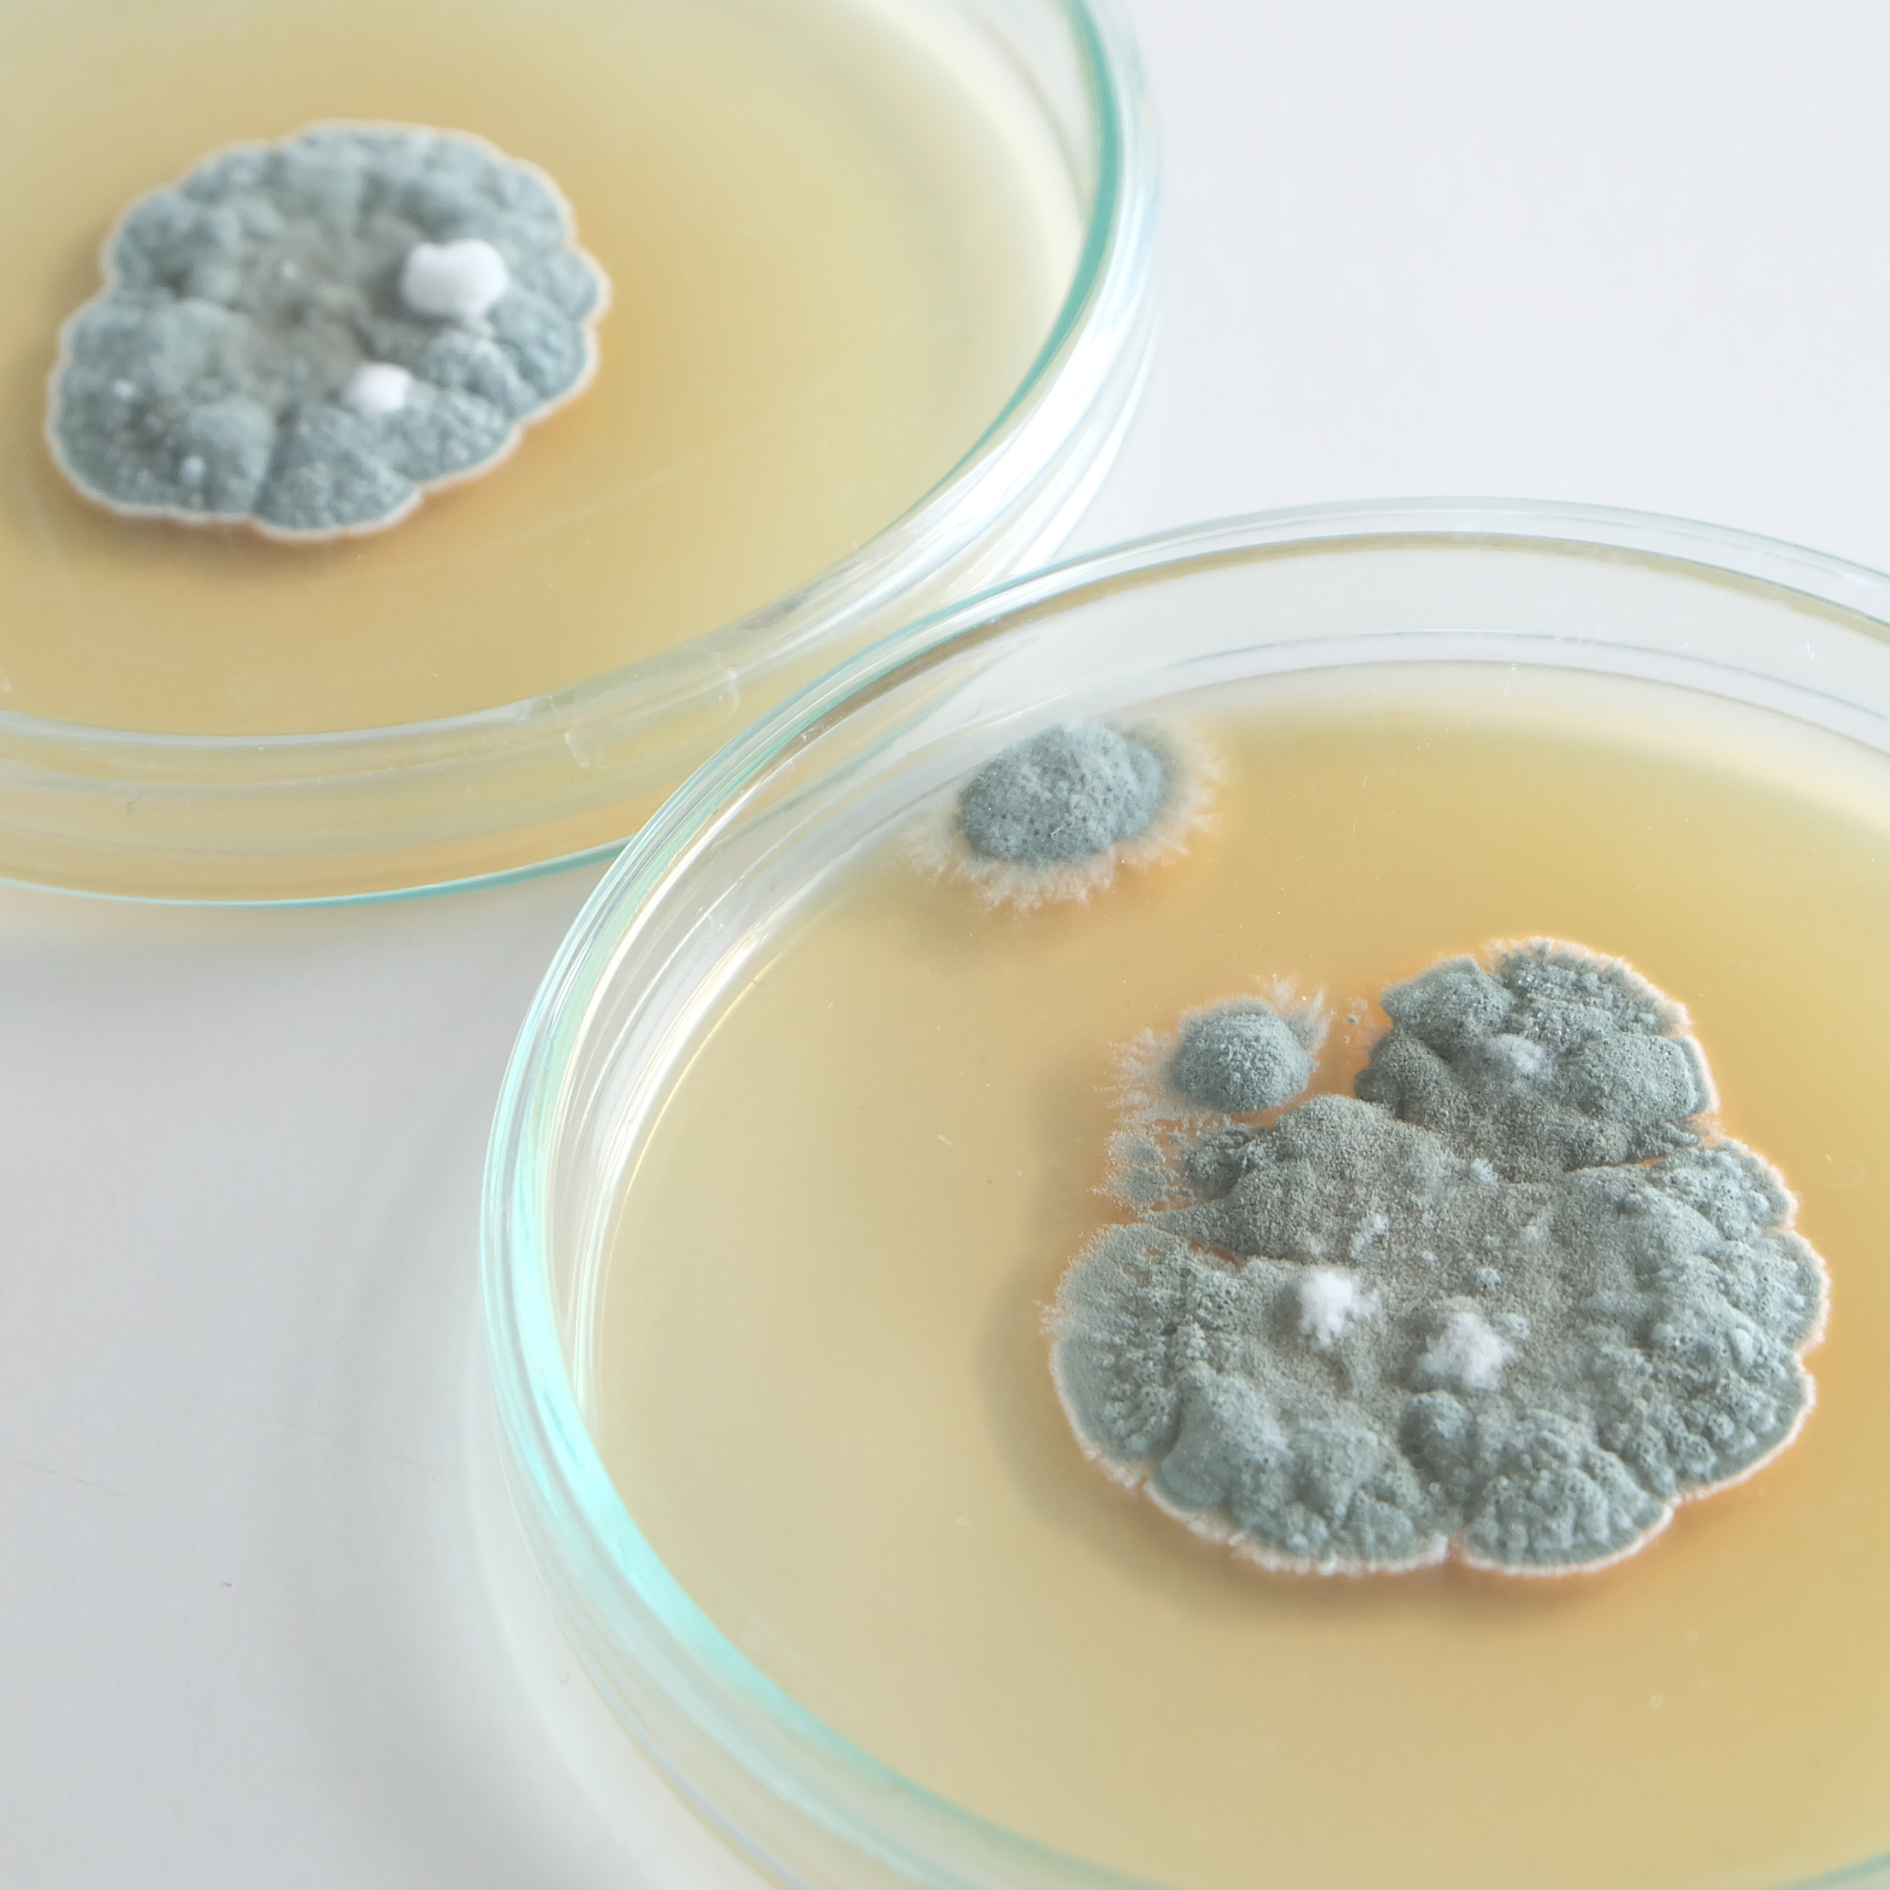
Penicillium in air coinditioners

Harmful Mould and Bacteria in Air Conditioners: Health Risks and Remediation
Air conditioners play a crucial role in maintaining indoor comfort, but they can also become breeding grounds for harmful mould and bacteria that pose significant health risks. In this informative blog, we will explore the types of mould and bacteria that thrive in air conditioning systems, their potential health implications, and effective strategies to eliminate or prevent their growth.
Types of Harmful Mould and Bacteria
Aspergillus
Aspergillus is a common indoor mould that can grow in air conditioning systems. It releases tiny spores into the air, which can be inhaled, leading to respiratory issues and allergies. Severe cases of Aspergillus exposure can result in invasive lung infections, especially in individuals with compromised immune systems.
Stachybotrys Chartarum (Black Mould)
Black mould is notorious for its dark, slimy appearance. It produces mycotoxins, which can be toxic when inhaled or touched. Exposure to Stachybotrys chartarum can lead to respiratory problems, headaches, and skin irritation. Prolonged exposure may cause more severe health issues.
Legionella pneumophila (Legionnaires' Disease)
Legionella bacteria can proliferate in air conditioning systems, particularly in cooling towers. Inhalation of contaminated aerosols can lead to Legionnaires' disease, a severe form of pneumonia. Symptoms include high fever, cough, and muscle aches. In extreme cases, it can be fatal.
Health Risks Associated with Mould and Bacteria in Air Conditioners
Exposure to these harmful moulds and bacteria can lead to various health problems, including:
Respiratory Issues
Inhaling mould spores and bacteria can cause or exacerbate respiratory conditions such as asthma, bronchitis, and allergic rhinitis.
Allergies
Mould and bacteria can trigger allergic reactions, resulting in symptoms like sneezing, coughing, watery eyes, and skin rashes.
How to Get Rid of Harmful Mould and Bacteria in Air Conditioners
1. Regular Deep Cleaning:
The first step in preventing and eliminating mould and bacteria in your air conditioner is to ensure regular deep cleaning. This includes cleaning filters, cleaning coils, and checking for leaks or condensation issues. Regular deep cleaning helps reduce moisture levels, which are conducive to mould and bacterial growth.
2. Clean Air Ducts and Vents:
Cleaning air ducts and vents is essential for preventing the spread of mould and bacteria throughout your home. Hire a professional duct cleaning service to remove accumulated dust, debris, and contaminants.
3. Control Humidity Levels:
Maintaining optimal humidity levels in your home (typically between 30-50%) discourages mould and bacteria growth. Use dehumidifiers, especially in damp areas like basements, to control moisture.
5. Consider Air Purifiers:
High-quality air purifiers with HEPA filters can capture mould spores and bacteria, preventing them from circulating in your indoor air.
7. Professional Inspection and Cleaning:
If you suspect a severe mould or bacteria infestation, it's crucial to hire a professional to inspect and clean your air conditioning system thoroughly. They can identify and address the root cause of the problem.
Harmful mould and bacteria in air conditioning systems can pose serious health risks, particularly when left unchecked. Regular deep cleaning, humidity control, and professional inspections are essential steps to prevent and eliminate these contaminants. By taking proactive measures, you can ensure that your air conditioner not only provides comfort but also promotes a healthy indoor environment for you and your family. Prioritise your health by safeguarding your home against the dangers of mould and bacteria in air conditioning systems.